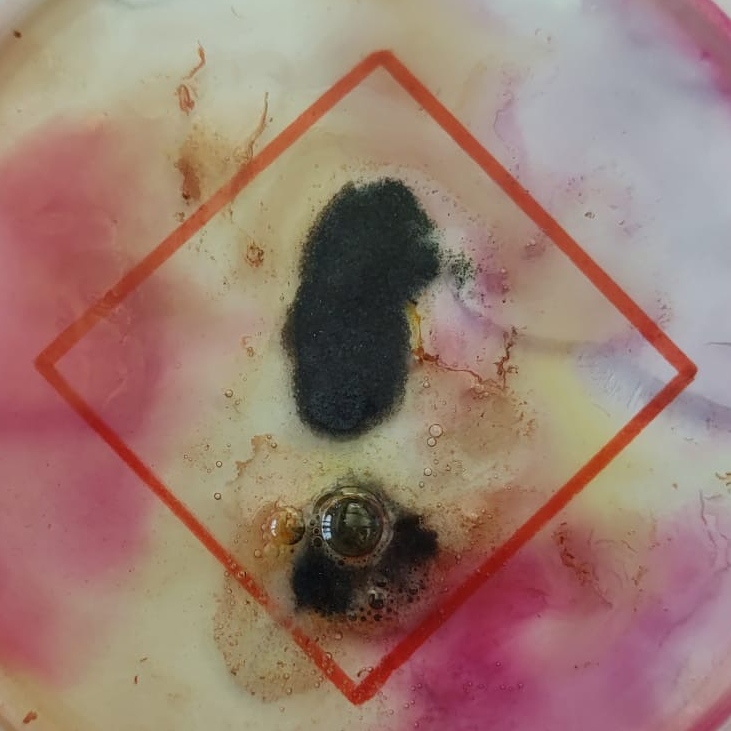
Bild aus dem Chemischen Fotokalender: Bunte Flüssigkeit, die aussieht wie ein Gefahrenpiktogramm

Chemischer Fotokalender

Übersicht
Überblick
Schlüsselwörter: Experimente, selbstständig, kreativ, Fotos, Kalender, Chemie
Disziplinen: Chemie (auf weitere naturwissenschaftliche Fächer übertragbar), Kunst
Altersstufe der Schüler*innen: Sekundarstufe II
Zeitrahmen: etwa 3 Doppelstunden

Dieses Unterrichtsprojekt von Ina Bischof wurde beim Nationalen Science on Stage Festival 2023 in Bayreuth vorgestellt. In diesem Unterrichtsmaterial wird ein Fotokalender zu Chemieexperimenten erstellt. Es eignet sich besonders gut zum Einsatz mit heterogenen Lerngruppen, zur Wiederholung von Unterrichtsinhalten und zum selbstorganisierten Lernen.
Überblick
In diesem Projektvideo vom Nationalen Science on Stage Festival erhalten Sie einen kurzen Überblick über das Projekt.
Hier finden Sie das Projektposter zum Chemischen Fotokalender vom Nationalen Science on Stage Festival.
Das Projekt „Chemischer Fotokalender“ wird im Chemieunterricht durchgeführt. In Anlehnung an den Bildungsplan wird das Thema durch die Lehrkraft festgelegt und die Experimente entsprechend ausgewählt. Grundsätzlich kann das Projekt in allen Klassenstufen durchgeführt werden. Schüler*innen der Kursstufe sind selbstständiger beim Experimentieren, deswegen eignet sich das Projekt in besonderem Maße für die Oberstufe.
Die Lehrkraft kann verschiedene Schwerpunkte bei der Durchführung des Projekts setzen:
- Begeisterung für Chemie
- Kennenlernen neu zusammengesetzter Lerngruppen
- Förderung von Individualität und Selbstständigkeit
- Bleibende Erinnerung an den Chemieunterricht
- Wiederholung eines bekannten Unterrichtsthemas, alternativer Zugang zu einem neuen Unterrichtsthema oder vertiefend Übung zu einem aktuellen Unterrichtsthema
Die Lehrkraft entscheidet, wie viel Verantwortung sie an die Lerngruppe überträgt. Dabei kann die Aufgabenstellung geöffnet oder geschlossen werden durch
- die Vorauswahl der Experimente und durch die Experimentieranleitung
- die endgültige Zusammenstellung des Kalenders mit der Bildauswahl
- die Entscheidung, ob und wie die Schüler*innen die Experimente präsentieren.
Der Zeitbedarf ist abhängig vom gewählten Schwerpunkt und dem Grad der Offenheit der Aufgabenstellung (zwischen zwei und vier Doppelstunden).
Benötigte Materialien
- Je nach Wahl des Themas entsprechende Chemikalien und Laborausstattung
- Kameras (Handykameras der Schüler*innen)
Projektverlauf
Das Projekt „Chemischer Fotokalender“ wird üblicherweise in drei Phasen durchgeführt. Je nach Grad der Offenheit variiert vor allem der Zeitbedarf für die erste und dritte Phase.
In der ersten Phase wird das Projekt vorgestellt. Die Experimente können eigenständig recherchiert werden oder werden kurz vorgestellt. Jede Schülergruppe wählt die Experimente selbstständig und in Absprache mit der Lerngruppe aus. Die Gruppe einigt sich auf ein gemeinsames Bildformat (siehe Zusatzmaterial).
Ziel
Ästhetische Fotos von Experimenten für einen gemeinsamen Fotokalender
Vorgehen
Entscheide dich mit einer Gruppe für ein Themengebiet.
Es ist sinnvoll, jedes der Experimente erst einmal durchzuführen. Überlege dann, wie das Experiment mit einem Foto präsentiert werden kann. Der Arbeitsaufwand für die Experimente ist sehr verschieden. Sobald deine Gruppe mit dem Fotoergebnis zufrieden ist, wählst du dir ein weiteres Experiment aus.
Bemerkungen zu den Bildern
- Beachte, dass die Bilder für den Kalender ein quadratisches Format haben werden.
- Achte auf eine gute Bildqualität, Standbilder von Filmaufnahmen haben für den Fotokalender eine zu schlechte Qualität.
- Überlege, ob du das Reaktionsprodukt dokumentieren möchtest. Soll die Ästhetik im Vordergrund stehen oder eine interessante Beobachtung?
- Überlege, ob du den Reaktionsverlauf dokumentieren möchtest. Kann man die Beobachtung einer Wärmeentwicklung, einer Gasentwicklung oder Farbveränderungen durch die Wahl des Zeitpunkts des Bildausschnitts oder den Ausschnitt besonders unterstützen?
- Mache dir Gedanken über den Hintergrund: Gefahrenpiktogramme, Arbeitsmaterialien, neutral, Natur, bewusst kein Hintergrund, Arbeitstisch.
- Eignet sich dein Motiv besonders gut für eine Jahreszeit, einen Monat? Wenn ja, überlege, wie dies deutlich wird. Kläre ab, ob es nicht bereits ein Bild zu einem bestimmten Monat gibt.
- Vergleiche deine Fotos mit denen der anderen Gruppen. Unterstützt euch gegenseitig.
Das Zusatzmaterial finden Sie als Infoblatt für die Schüler*innen hier zum Download als docx und als pdf.
In der zweiten Phase arbeiten die Schüler*innen beim Praktikum in Kleingruppen. In dieser Phase soll der Lerngruppe bewusst werden, dass die Experimente so häufig durchgeführt werden können, bis sich ein geeigneter Moment der Aufnahme und ein sinnvoller Bildausschnitt herauskristallisiert haben. Die eingesetzten Mengen der Chemikalien und die Wahl der Materialien darf dabei variiert werden. Es steht nicht die vollständige Dokumentation des Experiments im Fokus, sondern die ästhetische Darstellung. Das Arbeitstempo der Gruppen ist verschieden und auch stark davon abhängig, wie aufwändig die Versuchsvorbereitungen und wie „fotogen“ das Experiment ist. Diese Phase benötigt erfahrungsgemäß bei jeder Form der Aufgabenstellung und der Schwerpunktsetzung knappe zwei Doppelstunden.
In der dritten Phase wird der Kalender zusammengestellt. Gemeinsam wird die endgültige Bildauswahl getroffen und die Reihenfolge der Bilder festgelegt. Je nach Schwerpunkt der Experimente im Unterrichtsgang können zu den Bildern Bildunterschriften oder ausführliche Texte zur Erklärung formuliert werden. Möglich ist auch eine Präsentation mit Beobachtungen, Auswertung und der zugrundeliegenden Theorie des Experiments.
Hinweise zur Umsetzung
Mit Hilfe von drei Beispielen werden Ihnen drei methodische Variationen vorgestellt, die sich durch die Offenheit der Aufgabenstellung unterscheiden. Die Methode ist auf jedes der vorgestellten Themen übertragbar. Bitte beachten Sie, dass die Ergebnisse von Lerngruppe zu Lerngruppe sehr verschieden sind, denn das Unterrichtsprojekt hat das Ziel, die Kreativität der Schüler*innen anzuregen und daher wird sich jedes Kalenderprojekt unterscheiden.
Was den Schüler*innen an diesem Unterrichtsprojekt besonders gefallen hat, erfahren Sie im Projektvideo.
1. Beispiel für eine offene Aufgabenstellung: Die Entwicklung des Säure-Base-Begriffs
Unterrichtsinhalte und Lernziel
Inhalte: Rotkohlindikator (Farbspektrum), Universalindikator, Zerlegung von Wasser
Lernziel: Aktivierung des Vorwissens des Säure-Base-Begriffs aus Klasse 10

Im Schuljahr 2020/21 wurde das Projekt „Chemischer Fotokalender“ erstmals durchgeführt. Nach einer langen Phase des Fernunterrichts war das Bedürfnis nach gemeinsamer Unterrichtszeit mit vielen praktischen Anteilen beim Basiskurs und der Lehrkraft sehr groß. Die Schüler*innen kannten sich teilweise noch nicht und das Vorwissen war sehr unterschiedlich. Der Basiskurs Chemie (Klasse 11, G8) war aus vielen sehr lernwilligen, kreativen und gut organisierten Schüler*innen zusammengesetzt. Während des Projekts hatten alle das Gefühl, richtig schöne Unterrichtsstunden zu erleben.
Die Lerngruppe hat sich zu großen Teilen selbst organisiert und die Selbstständigkeit im positiven Sinn genutzt. Trotzdem war zu jeder Zeit ein Gefahrenbewusstsein beim Umgang mit Gefahrstoffen vorhanden. Kritische Experimentierphasen wurden von mir engmaschig begleitet. Für den Basiskurs war das Projekt und der entstandene Kalender ein Highlight des Schuljahres.
Im Zusatzmaterial ist der Unterrichtsverlauf beschrieben.
Methode
Offene Aufgabenstellung
Thema
Die Entwicklung des Säure-Base-Begriffs
Übergeordnete Ziele
- Wiederholung des Säure-Base-Begriffs in einer heterogenen Lerngruppe
- Schüler*innen sollen durch das Projekt für praktisches Arbeiten begeistert werden.
- Neu zusammengesetzte Lerngruppen soll sich durch das Projekt kennen lernen.
Lernziel
Aktivierung des Vorwissens des Säure-Base-Begriffs aus Klasse 10
Bemerkungen bei den Unterrichtsphasen
Phase 1
Dauer: Eine Doppelstunde
Gemeinsam und später auch in Kleingruppen werden Experimente gesammelt. Vorwissen, Neugier und Impulse durch die Lehrkraft bestimmen die Recherche. Die Kleingruppen dürfen „ihre“ Experimente selbst auswählen. Das Interesse der Schüler*innen steht bei der Verteilung der Experimente im Vordergrund, Kompromisse und Absprachen werden durch die Lehrkraft eingefordert.
Ideen der Schüler*innen:
- Herstellung und Verwendung von Rotkohlindikator (Farbspektrum)
- Universalindikator bei Naturstoffen wie Zitrone, Seife und bei sauren und alkalischen Flüssigkeiten aus dem Haushalt
- Reaktion von Salzsäure mit Natronlauge
- Reaktion von Essig mit Natron
- Reaktion von Natrium mit Wasser
- Zerlegung von Wasser in Oxonium-Ionen und Hydroxid-Ionen mit Hilfe von elektrischer Energie
Impulse:
- Der gelbe Farbstoff von Textmarkern ist abhängig vom pH-Wert
- Salzsäure und Ammoniak reagieren zu Ammoniumchlorid
- Wasserperlen (Gel-Kügelchen für Blumenvasen, um Schnittblumen feucht zu halten) mit Rotkohlindikator
Phase 2
Dauer: Zwei Doppelstunden
Jede Gruppe startet mit einem Experiment, schnellere Gruppen arbeiten an weiteren Experimenten und koordinieren die bisherigen Ergebnisse.
Gefahrenhinweis!
Beim Arbeiten mit konzentrierten sauren und alkalischen Lösungen muss bei der Durchführung des Experiments eine Lehrkraft anwesend sein bzw. den Versuch selbst durchführen. Die Lehrkraft muss sich vor der der Durchführung der Experimente in Phase 2 über mögliche Gefahren im Umgang mit den Chemikalien informieren und die Gefährdung beurteilen.
Phase 3
Dauer: Eine Doppelstunde
Einigung auf die endgültige Bildauswahl, die Hintergrundfarbe des Kalenders und die Reihenfolge der Bilder. Durch die Lehrkraft wurden die Bilder den Oberthemen zugeordnet. Die Auswahl der Bilder spiegelte die historische Entwicklung wider. Besonders zeitaufwändig war bei dieser Variante das Verfassen der Erklärtexte.
Erklärtexte zum Fotokalender: Die Entwicklung des Säure-Base-Begriffs
Im Folgenden sind die Kalenderbilder und die zugehörigen Erklärtexte der Schüler*innen zusammengestellt. Die Auswahl der Bilder spiegelte die historische Entwicklung wider.
Altertum
Schon im Altertum war der Essig bekannt, weil er bei der alkoholischen Gärung von Früchten durch Oxidation des gebildeten Alkohols entstand. „Essig“ und „sauer“ sind Begriffe, die von den Griechen fast gleichbedeutend gebraucht wurden. Das griechische Wort für Essig ist „oxos“, das für sauer „oxys“.

Auf dem Titelbild sieht man eine sauer schmeckende Zitronenscheibe, die mit Universalindikatorlösung versetzt wurde. Die rote Farbe zeigt an, dass es sich um eine saure Lösung handelt. Der Versuch wurde durchgeführt, um zu zeigen, dass Säuren auch im Alltag vertreten sind.

Das Januar-Bild zeigt ein angeritztes Stück Kernseife, das mit Universalindikatorlösung versetzt wurde. Die grün-blaue Farbe zeigt an, dass sie mit einer alkalischen Lösung überzogen ist. Kernseifen heißen auch Alkaliseifen. Im Arabischen bedeutet al-qalya „Pottasche“, dies ist ein Hinweis auf das Herstellungsverfahren von Alkaliseifen. Alkalische Lösungen wurden früher als Laugen bezeichnet, weswegen man auch heute noch teilweise den Begriff „Waschlauge“ verwendet.
17. Jahrhundert
Der irische Physiker und Chemiker Robert Boyle (1627 – 1691) führte im 17. Jahrhundert eine erste allgemeine Definition für Säuren ein. Für ihn war die Farbänderung einiger Pflanzenfarbstoffe durch Säuren ein wesentliches Kennzeichen von Säuren. Andere Forscher legten besonderes Gewicht auf die Fähigkeit, die Wirkung von alkalischen Lösungen aufzuheben.

Das Februar-Bild zeigt in Wasser gelösten Rotkohlsaft (=Rotkohlindikator) in verschiedenen Reagenzgläsern. Zu diesen wurden verschiedene verdünnte saure und alkalische Lösungen gegeben, wodurch unterschiedliche Färbungen entstehen, da auch die zugehörigen pH-Werte der Flüssigkeiten verschieden sind.

Das März-Bild zeigt Wasserperlen, die über Nacht in Rotkohlsaft eingelegt waren. Rotkohlsaft hat ein Farbspektrum von rot für eine saure Lösung über lila, blau, grün bis hin zu gelb für eine stark alkalische Lösung. Die gelben Perlen hatten anschließend Kontakt mit Natronlauge, die roten Perlen mit Salzsäure. Nach einiger Zeit hatten alle Wasserperlen die gleiche rötlichblaue Farbe.
Der Versuch darf nur in Anwesenheit der Lehrkraft durchgeführt werden.
Später lernte man Stoffe kennen, die zwar keine alkalischen Lösungen bilden, aber mit Säuren zu Salzen reagieren. Etwa ab 1730 tritt in Frankreich für diese Stoffe die Bezeichnung Base auf, da sie als Basis für die Salzbildung aufgefasst werden.
18. Jahrhundert
Antoine Laurent de Lavoisier (1743 – 1794), der Begründer der wissenschaftlichen Chemie, beobachtete, dass sich Nichtmetalle beim Verbrennen mit einem Bestandteil der Luft zu Stoffen verbinden, die sich in Wasser zu Säuren lösen. Den bei der Verbrennung gebundenen Luftbestandteil nannte er „gaz oxygène“, d. h. sauermachendes oder Säure bildendes Gas. Im Deutschen wurde dafür der Name Sauerstoff eingeführt. Nach Lavoisier enthielten alle Säuren Sauerstoff. Dieser Name wurde beibehalten, obwohl es inzwischen deutlich geworden ist, dass es Säuren auch ohne das Element Sauerstoff gibt.

Das April-Bild zeigt, dass bei der Reaktion von Alkali- und Erdalkalimetallen mit Sauerstoff in Anwesenheit von Wasser alkalische Lösungen entstehen. Natriumstücke schmelzen bei der Reaktion mit Wasser, da bei der Reaktion Wärme frei wird. Die Natriumstücke werden dadurch zu Natriumkugeln. Das entstehende Gas Wasserstoff treibt diese an, so dass sie sich auf der Wasseroberfläche hin und her bewegen. Bei des gebildeten Natriumoxids mit Wasser entsteht eine alkalische Lösung, dies wird durch die Farbänderung des Indikators im Wasserschweif der Natriumstücke sichtbar. Der Versuch darf nur in Anwesenheit der Lehrkraft durchgeführt werden.
19. Jahrhundert
Ende des 18. Jahrhunderts/Anfang des 19. Jahrhunderts war die Zusammensetzung einiger Säuren (z. B. Milchsäure, Citronensäure, Blausäure, Essigsäure) bekannt. Fest stand damit, dass alle bisher bekannten Säuren Wasserstoffverbindungen, aber nicht unbedingt Sauerstoffverbindungen sind. Im Jahr 1838 hielt Justus von Liebig (1803 – 1873) in einem Zeitschriftenartikel fest, dass Säuren Wasserstoffverbindungen sind, in welchen Wasserstoffatome durch Metallatome ersetzt werden können. Hierdurch entstehen Salze der Säuren.



Die Bilderfolge zeigt die Reaktion von einem Teelöffel Backpulver mit etwas konzentriertem Haushaltsessig in einer Filmdose. Das entstehende Gas Kohlenstoffdioxid braucht mehr Platz, so dass sich der Deckel von der Filmdose löst und dann die Dose in die Luft katapultiert wird. Da die Reaktion sehr schnell abläuft, gab es bei den ersten Versuchen Schwierigkeiten beim Schließen der Filmdosen.

Das Mai-Bild zeigt die Neutralisation von verdünnter Salzsäure mit verdünnter Natronlauge. Das interessante Farbspiel entsteht durch die Zugabe von Universalindikatorlösung und Rotkohlsaft. Das entstehende Kochsalz löst sich in Wasser. Die Entstehung der Regenbogenfarben war unerwartet.
Auch beim Zusammenbringen einer Säure mit einem Metalloxid entsteht ein Salz, dabei bildet sich zudem Wasser. Das Salz, das bei der Reaktion eines Metalls oder Metalloxids mit einer Säure entsteht, liegt normalerweise gelöst vor.
Svante Arrhenius (1859 – 1927) definierte im Jahr 1887 Säuren als Stoffe, die in Wasser Wasserstoff-Ionen (H+-Ionen) abspalten; Basen als Stoffe, die in Wasser Hydroxid-Ionen (OH- -Ionen) abspalten. Die Reaktion einer Säure mit einer Base wird als Neutralisation bezeichnet, deren wesentlicher Vorgang aus der Vereinigung von H+-Ionen und OH- -Ionen zu Wassermolekülen besteht.

Das Juni-Bild zeigt links verdünnte Natronlauge, die Hydroxid-Ionen enthält, die durch die Zugabe von Universalindikator ihre „typische“ blaue Färbung erhält. Die verdünnte Salzsäure rechts färbt sich aufgrund der enthaltenen Oxonium-Ionen durch die Zugabe von Universalindikator rot. Ein Nachteil des Säure-Base-Konzepts von Arrhenius bildet die Beschränkung des Base-Begriffs auf Hydroxide. Viele Stoffe, zum Beispiel Ammoniak, bilden alkalische Lösungen, obwohl sie keine Hydroxide sind.
20. Jahrhundert
Der Däne Johannes Nicolaus Brønsted (1879 – 1947) hat den Säure-Base-Begriff 1923 neu gefasst. Etwa zur gleichen Zeit wurde diese Neufassung auch von dem englischen Chemiker Thomas Martin Lowry (1874 – 1936) unabhängig von Brønsted vorgeschlagen. Teilchen, die bei einer Reaktion Protonen abgeben, nennt man Brønstedsäuren (Protonendonatoren). Teilchen, die bei einer Reaktion Protonen binden, nennt man Brønstedbasen (Protonenakzeptoren).
Einer konzentrierten Salzsäurelösung entweicht Chlorwasserstoff-Gas, einer konzentrieren Ammoniaklösung entweicht gasförmiger Ammoniak. Die beiden farblosen Gase reagieren unter Bildung von weißem, festen Ammoniumchlorid miteinander.

Das Juli-Bild zeigt, wie sich weißer Rauch bildet. Dabei reagieren Ammoniakmoleküle als Brønstedbase zu Ammonium-Ionen und Chlorwasserstoffmoleküle als Brønstedsäure zu Chlorid-Ionen. Der Versuch darf nur in Anwesenheit der Lehrkraft durchgeführt werden.

Wenn ein Wassermolekül ein Proton aufnimmt, bilden sich Oxonium-Ionen; gibt es ein Proton ab, so bildet sich ein Hydroxid-Ion. Im August-Bild sieht man, dass diese Reaktion stattfindet, wenn man eine elektrische Spannung an eine wässrige Lösung anlegt. Auf der linken Seite war die Flüssigkeit mit Rotkohlsaft versetzt, auf der rechten Seite mit Universalindikatorlösung (durch die Verwendung von viel Indikator und von Petrischalen statt U-Rohren als Reaktionsgefäß wurden die Fotografien eindrucksvoller).

Der pH-Wert zeigt die Konzentration der Oxonium-Ionen an. Bei einer Konzentration von 0,001 mol pro Liter ist der pH-Wert 3, denn die 1 steht an der dritten Stelle hinter dem Komma. Eine neutrale Lösung mit einem pH-Wert von 7 enthält 0,0000001 mol pro Liter. Das September-Bild zeigt Flüssigkeiten mit verschiedenen pH-Werten. Der pH-Wert wird hier durch die Farben des Indikators Bromthymolblau deutlich, vorausgesetzt man kennt die Bedeutung der Farben des jeweiligen Indikators.
Verwendete Chemikalien von links nach rechts: verdünnte Salzsäure, Essigsäure, Leitungswasser mit wenig Indikator, Leitungswasser mit viel Indikator, sehr verdünnte Natronlauge, verdünnte Natronlauge.
Vorsicht beim Umgang mit konzentrierten Säuren

Konzentrierte Schwefelsäure ist stark hygroskopisch, das bedeutet wasserentziehend. Das Oktober-Bild zeigt, dass konzentrierte Schwefelsäure in der Lage ist, dem Naturstoff Zucker Wasser zu entziehen; zurück bleibt schwarzer Kohlenstoff. Dabei wird so viel Wärme frei, dass das Wasser teilweise verdampft. Der Wasserdampf schäumt den Kohlenstoff auf, deswegen entsteht ein sehr poröser schwarzer Feststoff. Der Versuch muss von der Lehrkraft durchgeführt werden.

Auch Baumwollstoffe und einige Kunststoffe werden von konzentrierter Salzsäure zerstört. Sicherheitsmaßnahmen wie Schutzbrille und Schutzhandschuhe sind daher notwendig beim Umgang mit konzentrierten, starken Säuren. Das November-Bild zeigt die Wirkung von etwa 2 ml konzentrierter Schwefelsäure auf einen Haushaltsschwamm. Die Zugabe der konzentrierten Schwefelsäure ist von der Lehrkraft durchgeführt worden.
Eine unerwartete Base zum Schluss

Der gelbe Farbstoff von Textmarkern ist pH-Wert abhängig. Die gelbe Farbe verschwindet, wenn man die Farbe mit etwas Zitronensaft aus dem Haushalt versetzt. Bei orangefarbenen und grünen Textmarkern ist der gelbe Farbstoff beigemischt, so dass diese Farben ebenfalls verblassen. Durch die Protonenaufnahme in das Molekül des gelben Farbstoffs bildet sich eine farblose Verbindung. Das Dezember-Bild zeigt, dass diese farblose Verbindung im UV-Licht leuchtet.













2. Beispiel für eine geschlossenere Aufgabenstellung: Die Chemie der Kohlenhydrate
Unterrichtsinhalte und Lernziele
Unterrichtsinhalte: Glucose, Fructose, Ringbildung, glycosidische Bindung, Bildung von Zweifachzuckern
Praktikum: Benedict-Nachweis bei Glucoselösung, Fructoselösung, Cola und zuckerfreie Cola
Lernziele: Di- und Polysaccharide, Nachweisreaktionen, Verbrennung von Kohlenhydraten mit und ohne Katalysator, verschiedene Süßungsmittel

Im Schuljahr 2021/22 wurde das Projekt „Chemischer Fotokalender“ auf Wunsch desselben Basiskurses ein zweites Mal durchgeführt. Die Schüler*innen hatten in der Zwischenzeit viel praktische Erfahrungen gesammelt und waren es gewohnt, Lerninhalte selbstständig zu erarbeiten und ihre Ergebnisse zu präsentieren. Die Fotomotive wurden im Vergleich zum Vorjahr deutlich schneller gefunden. Das Projekt war so gestaltet, dass die Gruppen Präsentationen ausarbeiteten, um ihre Experimente und den chemischen Hintergrund den anderen zu zeigen und zu erklären. Die Präsentationen wurden alle im Unterricht gemeinsam vorbereitet, schnellere Gruppen kümmerten sich um weitere Fotos oder übernahmen die Auswahl und die Bestimmung der Reihenfolge der Fotos für den Kalender. Erneut war die Durchführung für alle Beteiligten ein Highlight des Schuljahres, weil die Selbstorganisation des Kurses überdurchschnittlich gut war, die Fotos gut gelangen und die Präsentationen (fast alle) sehr gut, kreativ und auf hohem Niveau waren.
Im Zusatzmaterial ist der Unterrichtsverlauf beschrieben.
Methode
Präsentationen zu Experimenten erstellen und Kalenderbilder fotografieren
Thema
Die Chemie der Kohlenhydrate
Übergeordnete Ziele
Die Individualität und Selbständigkeit fördern, da sich die Schüler*innen mit ihrem Vorwissen Lerninhalte selbst erarbeiten und dann präsentieren sollen.
Lernziele
Di- und Polysaccharide, Nachweisreaktionen, Verbrennung von Kohlenhydraten mit und ohne Katalysator, verschiedene Süßungsmittel
Bemerkungen bei den Unterrichtsphasen
Unterrichtsinhalte vor der Durchführung des Unterrichtsprojekts:
- Im Unterricht werden die Grundlagen der Chemie der Kohlenhydrate besprochen, konkret: Glucose, Fructose, Ringbildung, glycosidische Bindung, Bildung von Zweifachzuckern
- Praktikum: Benedict-Nachweis bei Glucoselösung, Fructoselösung, Cola und zuckerfreie Cola
Phase 1
Dauer: 1 Einzelstunde
Die Idee des Fotokalenders wird ausführlich besprochen.
Vorstellung von Präsentationsthemen, die in Gruppenarbeit erarbeitet werden sollen.
Phase 2
Dauer: 2 Doppelstunden
Die Schüler*innen erarbeiten sich die Theorie zu den vorgegebenen Experimenten. Sie recherchieren geeignete Versuchsanleitungen und führen nach Absprache mit der Lehrkraft das Experiment bzw. die Experimente durch (Sicherheitsbelehrungen). Die Experimentierphase wird durch Fotos dokumentiert und dabei entsteht auch das Bild für den Fotokalender. Im Anschluss erstellen sie eine Präsentation zu ihrem Thema.
Themen:
- Lolli-Herstellung – Lollis aus Isomalt, Süßungsmittel
- Zucker brennt - Schlange des Pharao sowie Rolle von Asche beim Entzünden
- Hefe braucht Zucker - Hefe-Versuch mit verschiedenen Zweifachzuckern
- Stärke-Nachweis - Aufbau von Stärke und Nachweis
- Mehlstaubexplosion und Stärkebrei - Aufbau von Stärke und nichtnewtonsche Flüssigkeit
- Papier schöpfen - Papierherstellung und Aufbau von Cellullose
Differenzierung für schnelle Gruppen:
Weitere Aufnahmen von bunten zuckerumhüllten Kaudragees bzw. Schokolinsen, in Wasser, Saccharose-Modell, Dichte mit Cola-Dosen (Cola und zuckerfreie Cola), Silberspiegelprobe
Gefahrenhinweis!
Das Erstellen von Gefahrstoffbeurteilungen ist vor der Durchführung der Experimente in Phase 2 notwendig. Bei der Durchführung der Versuche zum Verbrennen von Zucker (Schlange des Pharao) und der Mehlstaubexplosion muss die Lehrkraft anwesend sein.
Phase 3
Dauer: 2 Doppelstunden
Die Schüler*innen präsentieren ihre Ergebnisse. Die Präsentationen haben den Aufbau:
- Experiment wird vorgestellt und ausgewertet (Fotos unterstützen die Erklärungen)
- das ausgewählte Foto wird gezeigt
- die Theorie hinter dem Experiment/den Experimenten wird vorgestellt.
Im Anschluss wird der Fotokalender zusammengestellt.
Präsentationsthemen zum Projekt: Die Chemie der Kohlenhydrate
Im Folgenden sind die Präsentationsthemen zum Projekt mit den Fotos der Schüler*innen zusammengestellt.
Jede Gruppe wählt ein Thema aus, führt das Experiment/die Experimente durch und erstellt eine Präsentation. Schnellere Gruppen dürfen sich weitere Fotomotive auswählen oder bei der Zusammenstellung des Kalenders helfen (Auswahl, Bildunterschriften, Reihenfolge).
Gruppe 1: Lolli-Herstellung

Experiment und Fotomotiv
Lollis aus Isomalt: 100 g Isomalt im Edelstahltopf auf der Herdplatte schmelzen (höchste Heizstufe). Etwas abkühlen lassen, dann je nach Geschmack Zitronensäure (wenig), Aroma (je nach Konzentration) und Lebensmittelfarbe (wenig) dazu geben und verrühren. Kleine Kleckse auf ein Backpapier gießen und gleich Stiele (Zahnstocher) eindrücken. Erkalten lassen.
Präsentation
Dokumentation der Herstellung der Lollis sowie Information über Zuckeraustauschstoffe und Isomalt
Quellen
Internetrecherche, Schulbuch
Gruppe 2: Zucker brennt


Experimente und Fotomotive
- Weißer Würfelzucker brennt (mit Asche als Katalysator)
- Schlange des Pharao
Präsentation
Aufbau von Saccharose und Gewinnung von Zucker, Rolle der Asche als Katalysator, Reaktionsgleichung für die Verbrennung kurze Erklärung des Experiments zur Schlange des Pharao
Quellen
Schulbuch, Internetrecherche, Anleitung für das Experiment
Gruppe 3: Hefe braucht Zucker

Experiment und Fotomotiv
Hefe und verschiedene Zucker (mit Luftballons)
Präsentation
Erklärung des Experiments, Lactose-Molekül-Aufbau, Prinzip der Wirkungsweise von Enzymen am Beispiel der Lactase erklären
Quellen
Internetrecherche, Schulbuch, Anleitung für das Experiment
Gruppe 4: Stärke in Kartoffeln

Experiment und Fotomotiv
Stärkenachweis mit Iod-Kaliumiodid-Lösung mit verschiedenen Stärken und bei Kartoffeln
Präsentation
Information zum Aufbau der Amylose, Stärke in ungekochten und gekochten Kartoffeln, Nachweisreaktion erläutern, Einfluss der Wärme auf den Nachweis erklären
Quellen
Internetrecherche, Schulbuch
Gruppe 5: Mehlstaubexplosion und Stärkebrei

Experimente und Fotomotive
- Mehlstaubexplosion (Apparatur der Schule verwenden)
- Stärkebrei als Beispiel für eine nicht-newtonsche Flüssigkeit
Präsentation
Erklärung der Ursache von Mehlstaubexplosionen, Herstellung und Experimente mit dem Stärkebrei, Aufbau von Amylopektin und Glykogen
Der Versuch muss in Anwesenheit der Lehrkraft durchgeführt werden.
Quellen
Internetrecherche, Schulbuch
Gruppe 6: Papier-Herstellung

Experiment und Fotomotiv
Papier schöpfen
Präsentation
Prozess des Papierschöpfens - Fotodokumentation, Theorie zur Cellulose
Quelle
Internetrecherche, Schulbuch, Anleitung für das Experiment

Bunte zuckerumhüllte Kaudragees bzw. Schokolinsen in Wasser,
Anleitung für das Experiment

Silberspiegelprobe

Sacharose-Molekül bauen oder ein anderes Molekül bauen und aus interessantem Winkel fotografieren

Dose mit zuckerfreier Cola-Dose und Cola-Dose


Variationen des Benedict-Nachweises in mehreren Stufen der Durchführung (Cola, zuckerfreie Cola, Saccharose, Glucose im Vergleich)













3. Beispiel für eine geschlossene Aufgabenstellung: Redoxreaktionen
Lernziele
Lernziele: Aktivierung des Vorwissens zu Redoxreaktionen aus Klasse 10, Aufstellen von Redoxgleichungen üben und verschiedene Redoxreaktionen vergleichen
Im Schuljahr 2023/24 wurde das Projekt „Chemische Fotokalender“ in einem Leistungsfach durchgeführt (Abschlussklasse). Die Schüler*innen machten sich deutlich mehr Gedanken über die exakte Durchführung und die chemische Darstellung der Experimente. Sie gingen weniger spielerisch und zunächst auch weniger kreativ an die Aufgabenstellung heran. In Gesprächen mit den Kleingruppen entwickelten sie dann sehr gute Ideen für die fotografische Umsetzung. Die Umsetzung des Bildungsplans und das nahende Abitur war beim Leistungsfach stärker im Hinterkopf. Die Auswahl der Bilder und die Festlegung der Reihenfolge war von starker Ernsthaftigkeit geprägt. Mit dem Ergebnis waren alle sehr zufrieden.
Im Zusatzmaterial ist der Unterrichtsverlauf beschrieben.
Methode
Experimente durchführen und Kalenderbilder fotografieren
Thema
Redoxreaktionen
Übergeordnete Ziele
- alternativer Zugang zu Redoxreaktionen
- bleibende Erinnerung
Lernziele
Aktivierung des Vorwissens zu Redoxreaktionen aus Klasse 10, Aufstellen von Redoxgleichungen üben und verschiedene Redoxreaktionen vergleichen (Gemeinsamkeiten und Unterschiede erkennen).
Bemerkungen bei den Unterrichtsphasen
Phase 1
Dauer: Einzelstunde
Die Idee des Fotokalenders wird ausführlich besprochen. Im Unterrichtsraum sind 15 Experimentierkästen mit Versuchsanleitungen vorbereitet und werden kurz vorgestellt.
Phase 2
Dauer: 1 Einzelstunde und 1 Doppelstunde
Durchführung der Experimente
Gefahrenhinweis!
Die Lehrkraft muss sich vor der der Durchführung der Experimente in Phase 2 über mögliche Gefahren im Umgang mit den Chemikalien informieren und die Gefährdung beurteilen. Der Inhalt der Experimentierkästen enthält lediglich eine Zusammenstellung der verwendeten Chemikalien.
Phase 3
Dauer: 2 Doppelstunden
Erarbeitung der theoretischen Grundlagen durch die Besprechung der Experimente, teilweise kurze Wiederholung der Experimente bzw. Ergänzung durch Lehrerexperimente.
Inhalt der Experimentierkästen zum Thema: Redoxreaktionen
Im Folgenden sind die Kalenderbilder mit den Inhalten der Experimentierkästen der Schüler*innen zusammengestellt.
Im Unterrichtsraum waren 15 Experimentierkästen mit Versuchsanleitungen vorbereitet.
1. Magnesium reagiert mit Salzsäure

Chemikalien
Magnesium (Band und Pulver), verdünnte Salzsäure, (auf Wunsch: Universalindikator)
Materialien
Reagenzgläser, (auf Wunsch: Petrischale), Pipette, Spatel
Versuchsdurchführung
Das unterschiedliche Verhalten von Magnesiumband und Magnesiumpulver in verdünnter Salzsäure vergleichen.
Bemerkung
Die Schüler*innengruppe wollte zusätzlich darstellen, dass sich bei der Reaktion der pH-Wert ändert und variierte das geplante Reagenzglas-Experiment. Das Foto stellt ein Gefahrenpiktogramm dar. Auf den Einsatz eines Magnesiumbandes wurde verzichtet.
2. Kupferbäumchen unter dem Mikroskop

Chemikalien
Verdünnte Kupferchlorid-Lösung, Zink-Plättchen
Materialien
Objektträger, Pipette, Deckgläschen, Mikroskop
Versuchsdurchführung
Ein Tropfen Kupferchlorid-Lösung auf den Objektträger tropfen, Deckgläschen vorsichtig darauf legen und seitlich ein Zink-Plättchen an das Deckgläschen schieben. Nach kurzer Wartezeit ist das Wachsen von Kupferbäumchen bereits ohne Mikroskop erkennbar. Mikroskopieren und fotografieren.
Bemerkung
Dieses Foto wurde ausgewählt, weil es an eine Winterlandschaft erinnert. Es gibt auch Aufnahmen, bei denen die Kupferbäume kupferfarben sind.
3. Einordnung von Aluminium in der Oxidationsreihe der Metalle

Chemikalien
Verdünnte Kupferchlorid-Lösung, verdünnte Zinkchlorid-Lösung, Aluminiumfolie, Zinnfolie, (Kupfersulfat-Lösung, Natriumchlorid-Lösung)
Materialien
3 kleine Bechergläser, Pipetten
Versuchsdurchführung
Becherglas 1: Aluminiumfolie in Kupferchlorid-Lösung
Becherglas 2: Zinnfolie in Kupferchlorid-Lösung
Becherglas 3: Aluminiumfolie in Zinkchlorid-Lösung
Bemerkung
Die ursprüngliche Idee des Experiments war, dass die Schüler*innen entdecken, dass Chlorid-Ionen die Aluminiumoxidschicht des Aluminiums zerstören. Aluminium reagiert erst nach der Zugabe von Natriumchlorid mit einer Kupfersulfat-Lösung. Zinnfolie und Zinkchlorid-Lösung waren für Vorversuche mit im Experimentierkasten. Dieses Foto wurde ausgewählt, weil der Gruppe die Bläschenbildung im linken und rechten Becherglas gefallen hat.
4. Elefantenzahnpasta

Chemikalien
Konzentrierte Wasserstoffperoxid-Lösung (30%), Spülmittel, Kaliumiodid, destilliertes Wasser
Materialien
2 kleine Bechergläser, Spatel, Waage, schmaler Standzylinder, Zeitungen als Unterlage
Versuchsdurchführung
In einen hohen Standzylinder werden 5 mL Spülmittel gegeben.
In einem Becherglas 1 werden 35 mL Wasserstoffperoxid-Lösung vorbereitet.
In einem Becherglas 2 werden 7,5 g Kaliumiodid in 7,5 mL dest. Wasser gelöst.
Die Inhalte der beiden Bechergläser werden zeitgleich in den Standzylinder mit dem Spülmittel gegossen.
Bemerkung
Das Foto wurde ausgewählt, weil den Schüler*innen die Dynamik durch die fliegende Elefantenzahnpasta besonders gut gefallen hat.
5. Gummibärchen in Kaliumpermanganat-Lösung

Chemikalien
Sehr verdünnte Kaliumpermanganat-Lösung (c = 0,0005 mol·L-1), Natronlauge (w=10%), Gummibärchen, evtl. destilliertes Wasser
Materialien
Petrischale, Pipetten, Pinzette
Versuchsdurchführung
In eine Petrischale gibt man 20 mL KMnO4-Lösung und 10 mL Natronlauge und rührt kurz um. Dann legt man ein Gummibärchen in die Mitte. Bei dieser Redoxreaktion wird Glucose zu Gluconsäure oxidiert.
Bemerkung
Die Reaktion erfolgt schnell. Eventuell die Reaktionslösung verdünnen, um die Farbeffekte besser zu sehen und mehr oder weniger umrühren.
6. Kaliumpermanganat bei verschiedenen pH-Werten

Chemikalien
Sehr verdünnte Kaliumpermanganat-Lösung (c = 0,0005 mol·L-1), Natronlauge (w=10%), Salzsäure (c=1mol·L-1), Natriumsulfitlösung (w=1%)
Materialien
Dreigeteilte Petrischale, Pipetten
Versuchsdurchführung
In alle Schalendrittel gibt man je 2 mL der Kaliumpermanganatlösung.
In Schalendrittel 1 zusätzlich 2 mL Natriumsulfitlösung.
In Schalendrittel 2 zusätzlich 2 mL Natronlauge und 2 mL Natriumsulfitlösung.
In Schalendrittel 3 zusätzlich 2 mL Salzsäure und 2 mL Natriumsulfitlösung.
Bemerkung
Beim ausgewählten Foto wurde in das dritte Schalendrittel noch nichts zur Kaliumpermanganat-Lösung hinzugefügt.
7. Kaliumpermanganat mit Wasserstoffperoxid (pH = 7)

Chemikalien
Sehr verdünnte Kaliumpermanganat-Lösung (c = 0,0005 mol·L-1), Wasserstoffperoxid-Lösung (30%-ige und 3%-ige), Glimmspan
Materialien
Reagenzgläser, Reagenzglasgestell, Feuerzeug
Versuchsdurchführung
Zwei Reagenzgläser werden mit jeweils 1 mL Kaliumpermanganat-Lösung gefüllt.
Reagenzglas 1: Zugabe von 1 mL 3%-iger Wasserstoffperoxid-Lösung und Durchführen der Glimmspanprobe
Reagenzglas 2: Zugabe von 1 mL 30%-iger Wasserstoffperoxid-Lösung
Bemerkung
Das Experiment darf nur in Anwesenheit und Unterstützung der Lehrkraft durchgeführt werden.
8. Kaliumpermanganat mit Wasserstoffperoxid (pH < 7)

Chemikalien
Sehr verdünnte Kaliumpermanganat-Lösung (c = 0,0005 mol·L-1), Wasserstoffperoxid-Lösung (3%-ige)
Materialien
Reagenzgläser, Reagenzglasgestell, Pipette (auf Wunsch: 3 Erlenmeyerkolben, 3 Pipetten)
Versuchsdurchführung
3 Bechergläser mit verdünnter Wasserstoffperoxid-Lösung etwa 2 cm hoch füllen und dann jeweils leicht angesäuerte verdünnte Kaliumpermanganat-Lösung zutropfen.
Bemerkung
Die Schüler*innen wollten den Prozess in einem Bild dokumentieren: Zugabe der farbigen Lösung, Abnahme der Farbintensität, farblose Lösung. Bewusste Wahl des herbstlichen Hintergrunds, um die farblose Lösung am Ende zu verdeutlichen.
9. Schießbaumwolle und Baumwolle brennen

Chemikalien
Schießbaumwolle, Baumwolle
Materialien
Feuerzeug, feuerfeste Unterlage
Versuchsdurchführung
Das Verhalten beim Entzünden von Schießbaumwolle und Baumwolle sollte verglichen werden.
Bemerkung
Das Experiment darf nur mit Unterstützung der Lehrkraft durchgeführt werden. Den Schüler*innen gefiel die brennende Baumwolle besser als das Experiment mit der Schießbaumwolle. Das ausgewählte Foto zeigt daher ausschließlich brennende Baumwolle in Form unseres Schul-Logos. Mit dem Foto kann man auch einen brennenden Weihnachtsbaum assoziieren.
10. Platinen ätzen

Chemikalien
Platine mit Schutzhülle auf dem Kupfer, Wasserstoffperoxid-Lösung (30%-ig), Schwefelsäure
Materialien
Becherglas, Werkzeug zum Anritzen, Pipette
Versuchsdurchführung
Die Schutzhülle wird mit dem Werkzeug eingeritzt. Die Platine wird für ca. 20 Minuten in eine angesäuerte Wasserstoffperoxid-Lösung getaucht (eventuell stärker ansäuern, falls sich keine Kupfer-Ionen bilden).
Bemerkung
Das Experiment zeigt die Reaktion vor dem Ansäuern. Das Foto wurde ausgewählt, weil die Blasenbildung in Kombination mit der Schutzfolie und dem schimmernden Kupfer den Schüler*innen besser gefiel als die anschließende trübe Reaktionsmischung.
11. Färben mit Indigo


Chemikalien
Wasser, Indigo, Natriumdithionit, Natronlauge (w=12%), Ethanol
Materialien
Waage, Thermometer, Reagenzglas, Becherglas (400 mL), Messzylinder, Glasrührstab, Heizplatte, ungefärbter Baumwollstoff
Versuchsdurchführung
250 mL Wasser und 20 mL Natronlauge in dem großen Becherglas mit Hilfe der Heizplatte auf 70° C erwärmen.
In einem Reagenzglas 0,5 g Indigo in 5 mL Ethanol lösen und zu der erwärmten Lösung geben.
Dem Farbbad unter ständigem Rühren 3 g Natriumdithionit bei einer Temperatur von etwa 70° C hinzufügen.
Die Stoffprobe in das Farbbad geben, kurz zum Sieden erhitzen. Unter Rühren bleibt die Stoffprobe ca. 15 Minuten im Farbbad. Anschließend wird sie mit Wasser ausgespült und getrocknet. Die Lösung kann über das Abwasser entsorgt werden.
Bemerkung
Von diesem Experiment wurden zwei Bilder ausgewählt, weil beide sehr gute sommerliche Motive darstellen. Der Blick von oben in das Becherglas wirkt wie eine Sonne. Der Blick von der Seite wie ein Weizenfeld mit Himmel.
12. Thermitverfahren (Wiederholung Mittelstufe)

Chemikalien
Thermitmischung, Papier, Wunderkerze, Feuerzeug
Materialien
Tiegel mit Deckel, Dreibein, kleiner Tiegel, Topf mit Sand
Versuchsdurchführung
Nur mit der Lehrkraft!
13. Eisenoxid reagiert mit Kohlenstoff (Wiederholung Mittelstufe)

Chemikalien
0,3 g feines Holzkohlepulver, 2g schwarzes Kupfer(II)-oxidpulver, Kalkwasser (w<1%)
Materialien
Dickwandiges Reagenzglas, gebogenes Glasrohr, Stopfen mit Loch, kleines Becherglas, Gasbrenner, Feuerzeug, Stativ, Klemme, Muffe, Filterpapier, Spatel, Waage
Versuchsdurchführung
Wiege 0,3 g feines Holzkohlepulver und etwa 2 g schwarzes Kupfer(II)-oxidpulver ab und vermische die Substanzen gründlich im Mörser. Fülle das Gemisch mithilfe eines Filterpapiers in ein dickwandiges Reagenzglas. Verschließe das Reagenzglas mit einem durchbohrten Stopfen, in dem ein gebogenes Glasrohr steckt. Erhitze das Gemisch in der rauschenden Brennerflamme. Fängt es an zu glühen, entferne die Flamme und halte das Ende des Glasrohres in Kalkwasser. Entferne das Glasrohr wieder aus dem Kalkwasser, wenn das Gemisch durchgeglüht ist. Lass danach das Gemisch abkühlen und schütte es auf ein Filterpapier.














Im Schuljahr 2022/23 wurde das Fotoprojekt in einer achten Klasse (Anfangsunterricht) durchgeführt. Es gab mehrere Schüler*innenpraktika, bei denen die Schüler*innen fotografieren durften:
- Verhalten von Lösungen
- Glas schmelzen
- Trennverfahren (Destillation von Rotwein, Abdampfen am Beispiel Salzwasser, Trennung von Ammoniumchlorid und Kohlenstoff)
- Untersuchung von Kerzenwachs
Zusätzlich entstanden auch Fotografien bei einer experimentellen Hausaufgabe zum Thema „Die Milch macht’s“. Besonders gelungene Fotografien wurden dann von der Lehrkraft für die Klasse zusammengestellt.
Bei dieser Variante wird die Selbstständigkeit der Schüler*innen nicht gefördert. Nur einige Schüler*innen haben schöne Fotografien für den Kalender erstellt, so dass der Kalender kein Gemeinschaftsprodukt im engeren Sinne ist.
Kooperationsmöglichkeiten
- Kooperationen mit externen Partnern wie Universitäten, Hochschulen und Pädagogischen Hochschulen sind möglich, falls dort entsprechend Teile der Fotos aufgenommen werden oder gemeinsam Experimente entwickelt werden.
- Die Kalender wurden auf der Schulwebseite des Albertus-Magnus-Gymnasiums veröffentlicht: Die Entwicklung des Säure-Base-Begriffs (2021), Die Chemie der Kohlenhydrate (2022), Begleitende Aufgabenstellung im Anfangsunterricht (2023), Redoxreaktionen (2024)
Fazit und weitere Ideen
- Persönliches Fazit: Das Unterrichtsgefühl ist bei der offenen Aufgabenstellung besonders schön. Auf Wunsch von Kolleg*innen wurden geschlossenere Aufgabenstellung mit den Experimentierkästen durchgeführt, um den Einstieg in die Projektidee für andere Lehrkräfte zu erleichtern.
- Das Projekt eignet sich zum Nachmachen in naturwissenschaftlichen Fächern.
- Es eignet sich auch als alternative Lernleistung, GFS (Gleichwertige Feststellung von Schülerleistungen) oder Projektarbeit eines Schülers bzw. einer Schülerin (je nach Bundesland).
- Grundsätzlich könnten die Fotokalender auch verkauft werden.
Quellen
- Fortbildungsmaterial der Pädagogischen Hochschule Karlsruhe zum Thema Redoxreaktionen
- Redoxreaktionen in Praktikum und Theorie, Zentrum für Schulqualität und Lehrerbildung (ZSL) Baden-Württemberg
- Schulbücher von Klett, Duden Paetec, Cornelsen
Weiterführende Links
- Kalender: Die Entwicklung des Säure-Base-Begriffs (2021)
- Kalender: Die Chemie der Kohlenhydrate (2022)
- Kalender: Begleitende Aufgabenstellung im Anfangsunterricht (2023)
- Kalender: Redoxreaktionen (2024)
- Projektvideo vom Nationalen Science on Stage Festival
- Projektposter vom Nationalen Science on Stage Festival
Über die Autorin
Ina Bischof ist Lehrerin für Chemie und Mathematik am Albertus-Magnus-Gymnasium in Ettlingen, Baden-Württemberg. Sie ist MINT-Beauftragte an ihrer Schule und engagiert sich zudem als Projektbetreuerin bei Jugend forscht.

Diese Seite teilen

